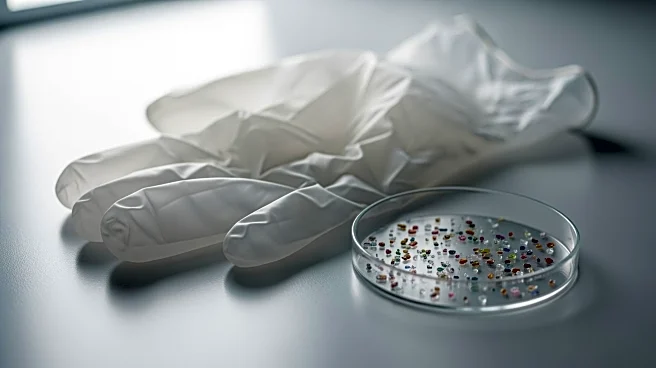
University of Michigan Study Reveals Lab Gloves May Skew Microplastics Data

What's Happening?
Researchers at the University of Michigan have developed protein-based nanoparticles capable of genetically modifying human cells without integrating genetic material into the genome. This advancement aims to reduce the risks associated with viral vectors,
such as secondary cancers and immune reactions. The nanoparticles, made using serum albumin and polyethylenimine, offer a safer alternative for gene therapy applications. In a proof-of-concept experiment, the team successfully modified human liver cancer cells, kidney cells, and immune cells by introducing genes for green fluorescent protein. The study, published in Advanced Materials, highlights the potential of these nanoparticles to deliver therapeutic genes without the side effects of traditional virus-based methods.
Why It's Important?
This development is significant as it addresses the safety concerns associated with current gene therapy techniques that use viral vectors. By avoiding the integration of genetic material into the genome, the risk of causing secondary cancers is reduced. This method could revolutionize gene therapy, making it safer and more accessible for treating various genetic disorders. The ability to deliver therapeutic genes without triggering immune responses or causing other adverse effects could lead to more effective treatments for diseases like sickle cell anemia and leukemia. The research also opens the door for further exploration into non-viral gene delivery systems, potentially expanding the range of treatable conditions.
What's Next?
Future studies will focus on testing the nanoparticles' ability to modify human cells with therapeutic genes and identifying potential side effects. Researchers aim to refine the technology to ensure its safety and efficacy in clinical settings. The development of 'one-and-done' treatments using CRISPR-Cas9 loaded nanoparticles is also a possibility, offering precise gene editing without the need for repeated interventions. As the technology progresses, regulatory approval and clinical trials will be necessary to bring these treatments to patients. Collaboration with pharmaceutical companies and healthcare providers will be crucial in advancing this promising approach to gene therapy.